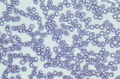
Mikroskop odwrócony Delta Optical IB-100

Mikroskop odwrócony Delta Optical IB-100
 Opis
Opis
Odwrócony mikroskop biologiczny do obserwacji w jasnym polu i kontraście fazowym z możliwością rozbudowy o kontrast fazowy z powiększeniem 400x oraz o zestaw do epifluorescencji (filtry B, G, U i V).
Zastosowanie: uczelnie, laboratoria, ośrodki naukowe, ochrona środowiska, medycyna, biologia, przegląd hodowli tkankowych i komórkowych hodowli umieszczonych np. w mikropłytkach i butelkach polistyrenowych, badanie osadów i obserwacja mikroorganizmów roślinnych i zwierzęcych, cytologia, mikrobiologia, parazytologia, badania planktonu itp.
- układ optyczny korygowany do nieskończoności
- nasadka trinokularowa typu Seidentopf o pochyleniu 30°, regulowana
- odległość między źrenicami w zakresie 48-75 mm
- adaptery do kamer: adapter 23,2 mm oraz adapter z gwintem c-mount
- regulacja ostrości w trzecim torze optycznym
- okulary z odrzuconą źrenicą (typu HP – high point) szerokopolowe WF10x/22 mm (2 szt.), okulary blokowane w tubusach za pomocą mikrowkrętów ampulowych
- niezależna regulacja dioptryjna w obu okularach +/- 5 dioptrii
- obiektywy planachromatyczne do kontrastu fazowego i jasnego pola (długość fokalna 45 mm, korygowane na grubość szkiełka 1,2 mm):
- * 4x / N.A. 0,1
- * PH 10x / N.A. 0,25
- * PH 20x / N.A. 0,4
- * 40x / N.A. 0,6
- Głowica rewolwerowa – pięciogniazdowa
- Kondensor – ELWD (Extra Long Working Distance) – N.A. 0,3, odległość robocza: 72 mm (bez kondensora 150 mm) z wsuwkami do kontrastu fazowego
- Centrowanie – teleskop centrujący (średnica 30 mm)
- Stolik – 160 mm x 250 mm z dodatkowym elementem o wymiarach 70 mm x 180 mm (rozszerzającym powierzchnię stolika); pełne wymiary 239 x 250 mm
- Uchwyt preparatu z regulacją przesuwu X-Y, zakres przesuwu preparatu 120 mm x 78 mm
- Okrągła płytka szklana do montażu na stoliku - Ø 110 mm z otworem Ø 46 mm
- Uchwyt preparatów z precyzyjną regulacją przesuwu X-Y, zakres przesuwu preparatu 120 x 78 mm
- Współosiowe pokrętła przesuwu preparatu umieszczone są pod stolikiem z prawej strony, pionowo, regulacja odległości pokręteł od stolika
- Uchwyt Terasaki
- Uchwyt szalek Petriego o średnicy 35 mm
- Uchwyt uniwersalny do szkiełek przedmiotowych i szalek Petriego o średnicy 54 mm
- Ogniskowanie – współosiowe pokrętła ruchu zgrubnego i drobnego, pionowy przesuw zgrubny – 37,7 mm na obrót, drobny – 0,2 mm na obrót (regulacja siły pokrętła makro)
- Filtry – niebieski, zielony i matówka o średnicy 45 mm
- oświetlacz halogenowy 6V/30W z regulacją jasności, zasilacz wbudowany w statyw mikroskopu
- wyposażenie: kabel zasilający, pokrowiec, zapasowa żarówka halogenowa, instrukcja w języku polskim
Specyfikacja
Nr katalogowy DO-3709
Rodzaj mikroskopu: biologiczny w układzie odwórconym
Zastosowanie: Uczelnie Wyższe, Laboratoria, Medycyna, Weterynaria
Technika obserwacji: jasne pole, kontrast fazowy
Głowica: trinokularowa
Podział światła w głowicy: 50:50 (okulary:tubus kamery)
Rewolwer obiektywowy: pięciogniazdowy
Obiektywy: PH10x PH20x 4x 40x
Powiększenie obiektywu: 40 x 20 x 10 x 4 x
Powiększenie okularu: 10 x
Pole widzenia okularów: 22 mm
Rozstaw źrenic: 48-75 mm
Kąt nachylenia tubusów okularowych: 30 °
Regulacja dioptrii: +/- 5D w obu tubusach
Powiększenia mikroskopu: 40 x 100 x 400 x 200 x
Kondensor: ELWD N.A. 0,3 WD 75 mm
Klasa optyki: planachromatyczna
Źródło oświetlenia: halogen
Moc oświetlenia: 30 W
Oświetlenie: przechodzące
Korekcja optyczna: nieskończoność
Wymiary stolika: 239 x 250 mm
Zakres ruchu mechanizmu przesuwu preparatu: 120 x 78 mm
Pokrętła regulacji ostrości: mikro, makro, dwustronne, współosiowe
Zasilanie mikroskopu: AC
Możliwość rozbudowy: kontrast fazowy, fluorescencja
Okres gwarancji: 24 miesiące
Wyposażenie
Filtry niebieski, zielony i matówka o średnicy 45 mm
teleskop centrujący do kontrastu fazowego
Uchwyt szalek Petriego o średnicy 38 mm
Uchwyt Terasaki
Uchwyt uniwersalny do szkiełek przedmiotowych i szalek Petriego o średnicy o średnicy 54 mm
wyposażenie: kabel zasilający, pokrowiec, zapasowa żarówka halogenowa, instrukcja w języku polskim